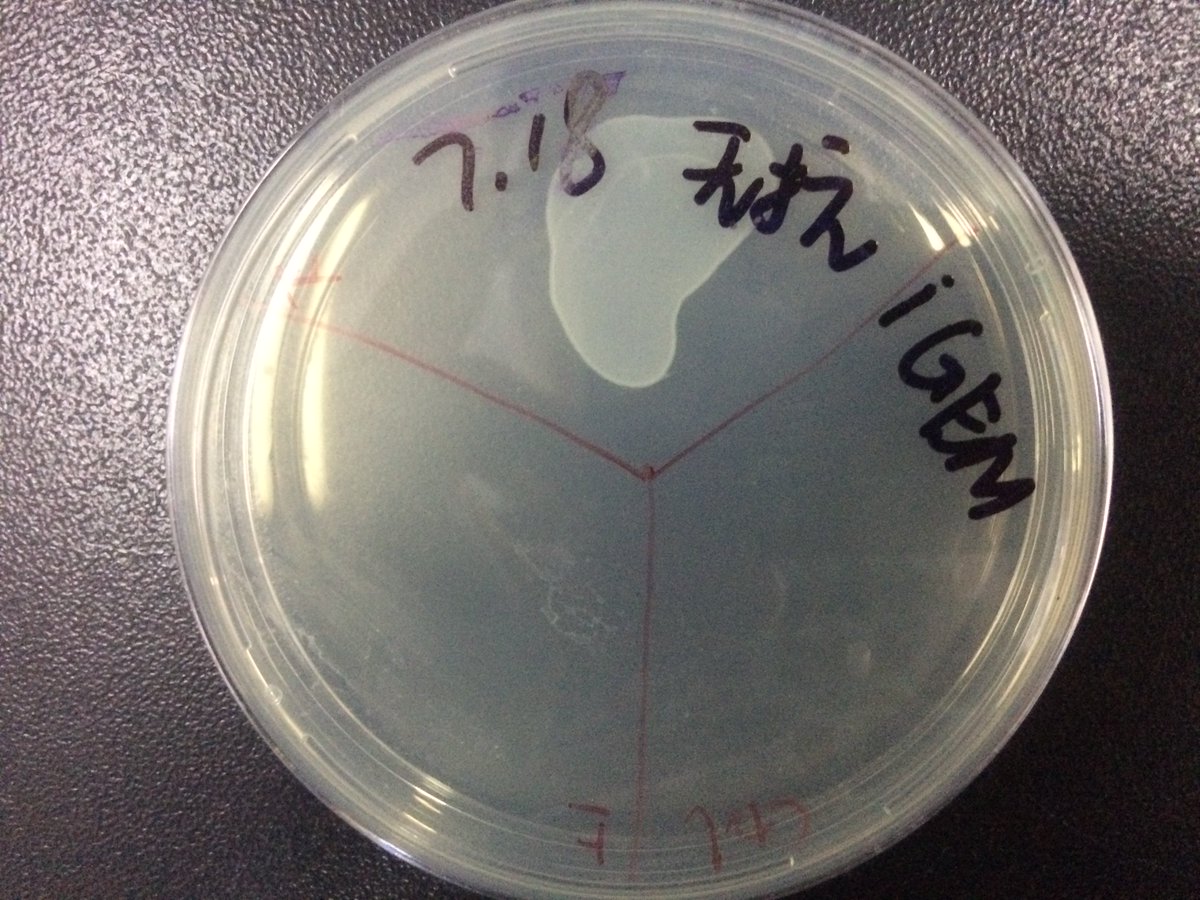
Working on Saturday!  And Wang was building our cool device...

SCU-WestChina2017
@scu_westchina
The twitter account of 2017 iGEM team "SCU-WestChina"! We're from West China Medical Center of Sichuan University, China.
ID: 854288141225558016
18-04-2017 10:58:59
72 Tweet
156 Takipçi
162 Takip Edilen














Here’s our video for iGEM 2017. WATCH OUR AWESOME VIDEO NOW! #TheLittlePCRGirl youtube.com/watch?v=rbg_2M… #iGEM2017 iGEM Headquarters

iGEM Headquarters SCU_China UESTC-China @Traci_H_Angelli

iGEM Headquarters @Traci_H_Angelli Thanks god we posted our video in Nov. 5th before deadline😂